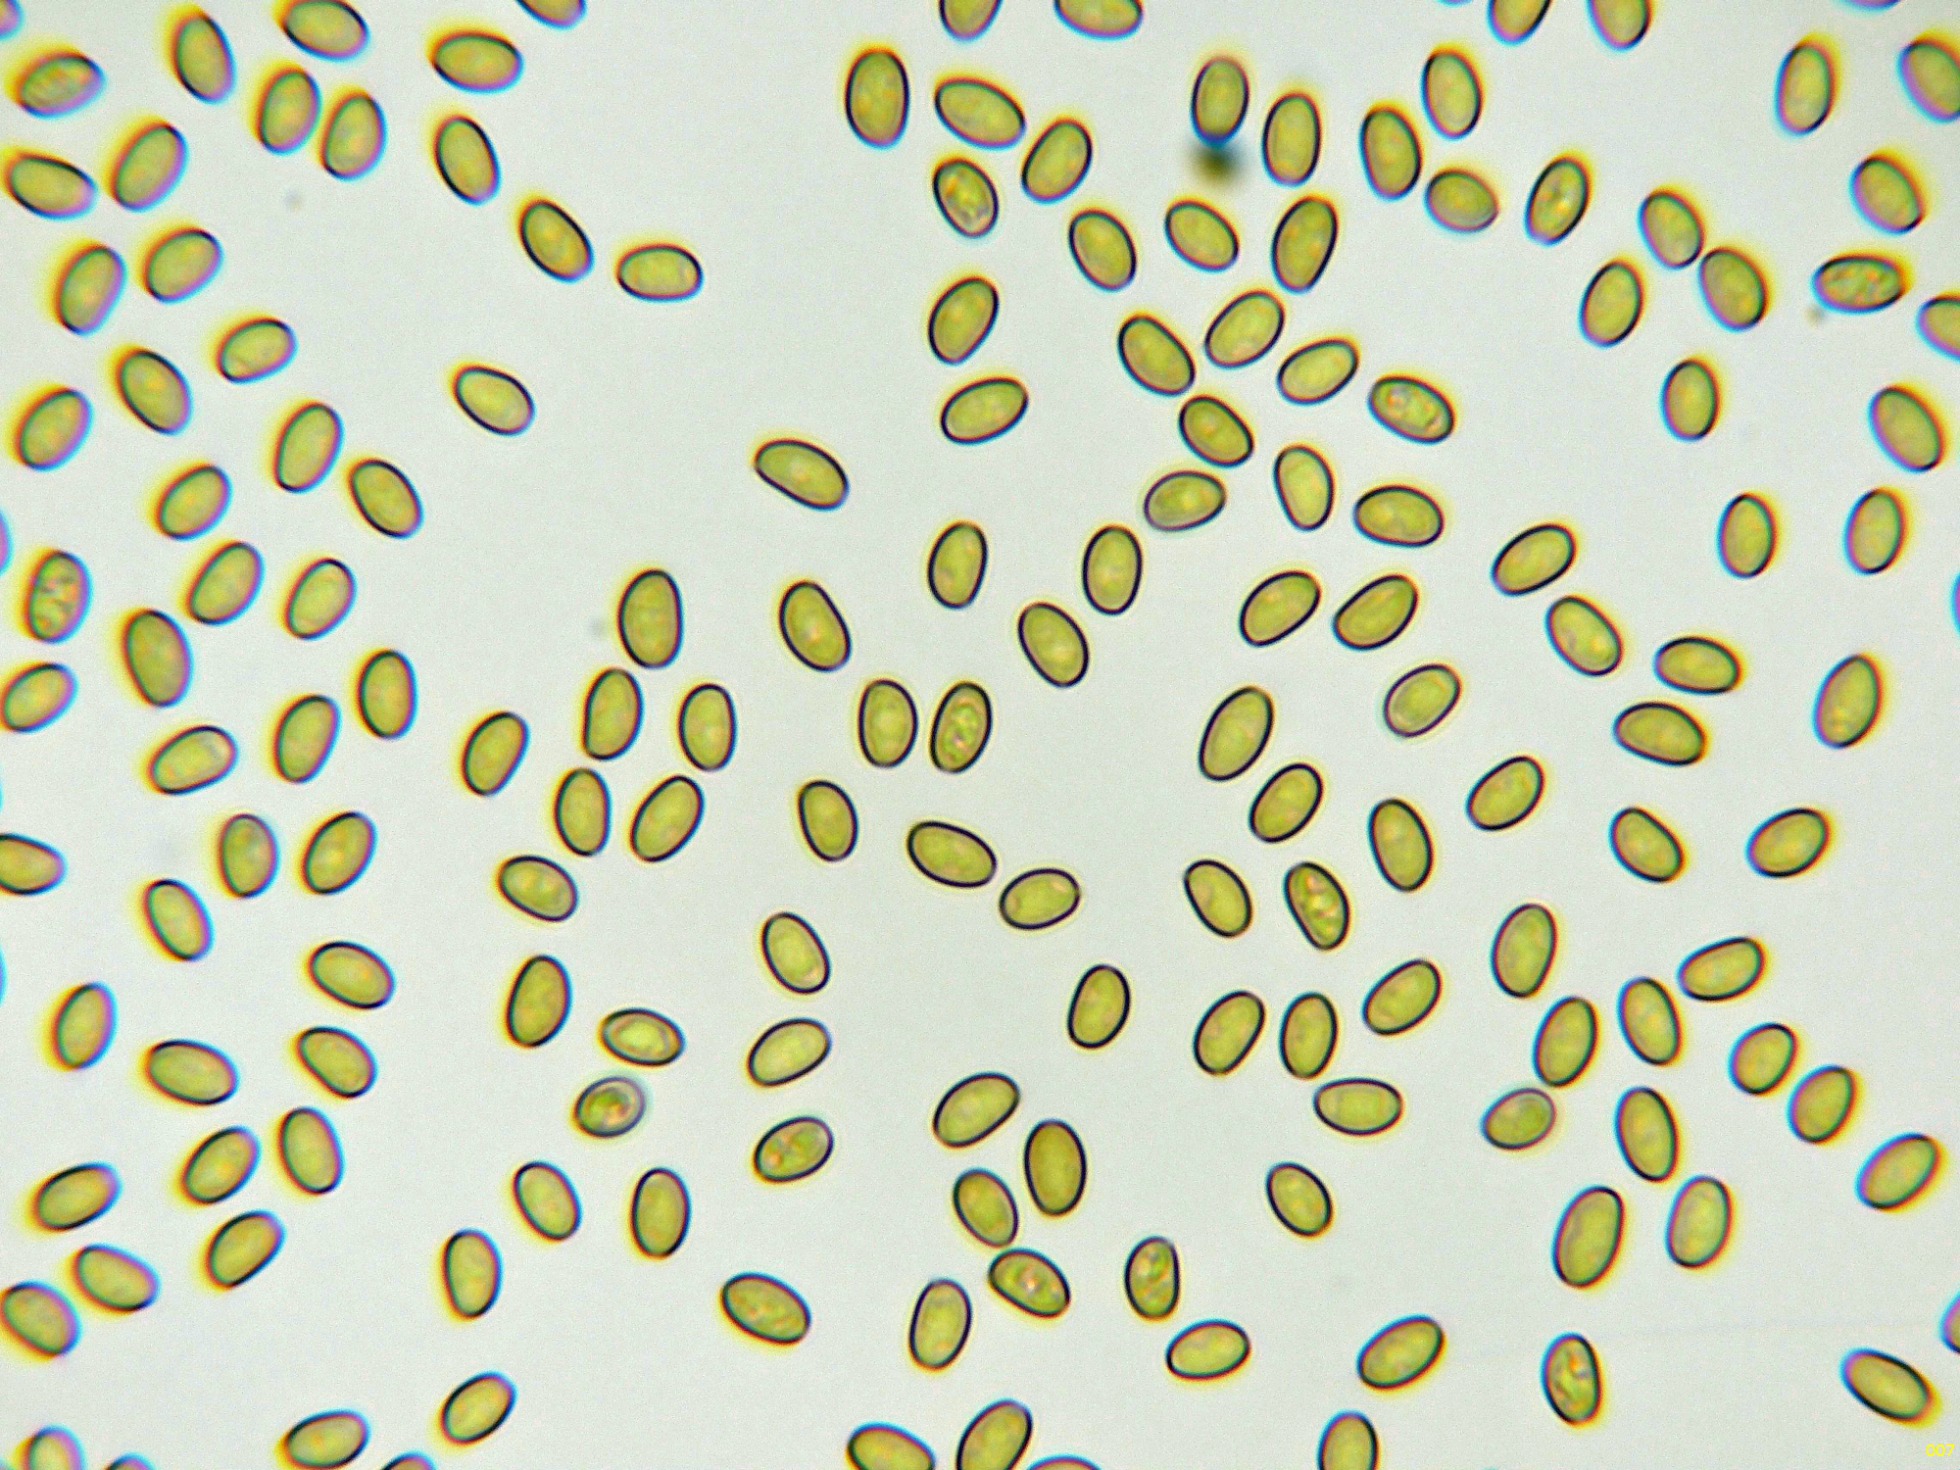

- Foro
- Foros sobre Micología de fungipedia
- Foro de bienvenida
- Pholiota squarrosa (Vahl) P. Kumm. Microscopía.
×
Bienvenido a fungipedia.es En este foro los miembros nos hablan acerca de ellos, ¿de donde eres?, ¿desde cuando te gusta la micología?, ¿que nivel de conocimientos tienes?, ¿porque te has convertido en miembro de este sitio? etc. ¡Damos la bienvenida a todos los nuevos miembros y esperamos verte pronto participando en nuestra web!
 Pholiota squarrosa (Vahl) P. Kumm. Microscopía.
Pholiota squarrosa (Vahl) P. Kumm. Microscopía.
- Josep Torres
-
 Autor del tema
Autor del tema
- Fuera de línea
- Moderador
-

Menos
Más
- Mensajes: 8732
- Gracias recibidas: 8378
1 año 4 meses antes #110293
por Josep Torres
Pholiota squarrosa (Vahl) P. Kumm. Microscopía. Publicado por Josep Torres
Hola a tod@s.
Una Pholiota fotografiada el pasado 12 de octubre, parasitando por completo el tronco de un árbol vivo, brotando de manera cespitosa y abundante por toda la circunferencia del tronco.
Pholiota squarrosa (Vahl) P. Kumm.
Detalle del pie escamoso y el abundante velo en la zona anular:
Las hifas de la suprapellis en agua:
Las hifas de las escamas del sombrero, con pigmento intracelular.
Los queilocistidios.
Los basidios de la cara laminar:
Las esporas en reactivo de Melzer, con un comportamiento dextrinoide:
Y por último las esporas en agua:
Estas esporas obtenidas por esporulación natural y en agua con unas medidas de:
(5.7) 6 - 6.9 (7.1) × (3.7) 3.9 - 4.4 (4.5) µm
Q = (1.4) 1.5 - 1.6 (1.7) ; N = 40
Me = 6.4 × 4.1 µm ; Qe = 1.6
Saludos a tod@s.
Una Pholiota fotografiada el pasado 12 de octubre, parasitando por completo el tronco de un árbol vivo, brotando de manera cespitosa y abundante por toda la circunferencia del tronco.
Pholiota squarrosa (Vahl) P. Kumm.
Detalle del pie escamoso y el abundante velo en la zona anular:
Las hifas de la suprapellis en agua:
Las hifas de las escamas del sombrero, con pigmento intracelular.
Los queilocistidios.
Los basidios de la cara laminar:
Las esporas en reactivo de Melzer, con un comportamiento dextrinoide:
Y por último las esporas en agua:
Estas esporas obtenidas por esporulación natural y en agua con unas medidas de:
(5.7) 6 - 6.9 (7.1) × (3.7) 3.9 - 4.4 (4.5) µm
Q = (1.4) 1.5 - 1.6 (1.7) ; N = 40
Me = 6.4 × 4.1 µm ; Qe = 1.6
Saludos a tod@s.
Adjuntos:
El siguiente usuario dijo gracias: Juan Andrés Román
Por favor, Identificarse para unirse a la conversación.
- Javi Calvo
-

- Fuera de línea
- Spammer
-

Menos
Más
- Mensajes: 7008
- Gracias recibidas: 2954
1 año 4 meses antes #110297
por Javi Calvo
Respuesta de Javi Calvo sobre el tema Pholiota squarrosa (Vahl) P. Kumm. Microscopía.
El siguiente usuario dijo gracias: Juan Andrés Román, Josep Torres
Por favor, Identificarse para unirse a la conversación.
- Josep Torres
-
 Autor del tema
Autor del tema
- Fuera de línea
- Moderador
-

Menos
Más
- Mensajes: 8732
- Gracias recibidas: 8378
1 año 4 meses antes #110299
por Josep Torres
Respuesta de Josep Torres sobre el tema Pholiota squarrosa (Vahl) P. Kumm. Microscopía.
El siguiente usuario dijo gracias: Juan Andrés Román
Por favor, Identificarse para unirse a la conversación.
- Foro
- Foros sobre Micología de fungipedia
- Foro de bienvenida
- Pholiota squarrosa (Vahl) P. Kumm. Microscopía.
Tiempo de carga de la página: 0.203 segundos

Foro de micología